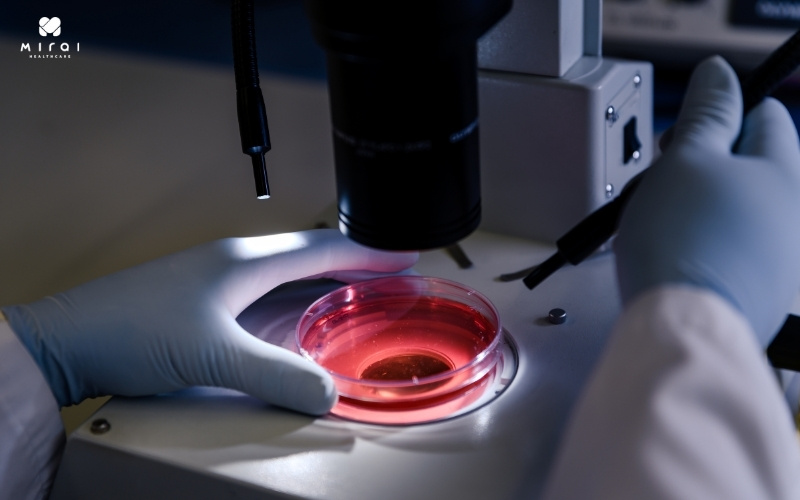
cay-mau-giup-phat-hien-vi-khuan-hoac-nam-trong-mau

Cấy máu là gì?
Trong những năm gần đây, số ca mắc nhiễm trùng huyết có xu hướng gia tăng nhanh chóng trên toàn cầu, trở thành một vấn đề y tế công cộng đáng lo ngại.
Đây là một tình trạng nhiễm trùng cấp tính nghiêm trọng, xảy ra khi vi khuẩn hoặc nấm xâm nhập vào máu, gây ra phản ứng viêm toàn thân mạnh mẽ.
Nhiễm trùng huyết có thể tiến triển nhanh chóng, dẫn đến sốc nhiễm khuẩn, rối loạn huyết động, suy đa cơ quan, và trong nhiều trường hợp là tử vong.

Xét nghiệm cấy máu giúp phát hiện nhiễm trùng huyết
Trong bối cảnh đó, cấy máu đóng vai trò thiết yếu trong chẩn đoán và quản lý nhiễm trùng huyết.
Đây là một xét nghiệm vi sinh học tiêu chuẩn, được sử dụng để phát hiện sự hiện diện của các vi sinh vật ngoại sinh trong máu.
Việc phát hiện và xác định chính xác tác nhân gây bệnh thông qua cấy máu không chỉ giúp khẳng định chẩn đoán mà còn đóng vai trò trung tâm trong việc lựa chọn kháng sinh phù hợp, theo dõi đáp ứng điều trị, và nâng cao khả năng cứu sống người bệnh.
Mục đích của cấy máu
Mục tiêu cơ bản nhất của cấy máu là phát hiện sự hiện diện của các vi sinh vật như vi khuẩn hoặc nấm trong dòng máu.
Thông qua cấy máu, vi sinh vật được phân lập và định danh để xác định chính xác tác nhân gây bệnh.
Đây là bước quan trọng để khẳng định chẩn đoán và định hướng tìm ổ nhiễm ban đầu, chẳng hạn như nhiễm trùng từ phổi, đường tiết niệu, ổ mủ trong ổ bụng hoặc da.
Sau khi phân lập được vi sinh vật, xét nghiệm tiếp theo là kháng sinh giúp đánh giá độ nhạy cảm của vi khuẩn đối với các loại kháng sinh. Điều này giúp bác sĩ lựa chọn thuốc kháng sinh phù hợp, hiệu quả, và ít gây hại nhất.
Cấy máu không chỉ có giá trị chẩn đoán mà có giá trị trong tiên lượng, theo dõi cho bệnh nhân.
Cấy máu dương tính kéo dài sau 48–72 giờ điều trị có thể là chỉ dấu của nhiễm trùng nặng, kháng thuốc hoặc thất bại điều trị, đặc biệt trong các bệnh lý như viêm nội tâm mạc nhiễm khuẩn hay nấm huyết.
Xem thêm: Xét nghiệm phết máu ngoại biên quan sát qua kính hiển vi
Cấy máu giúp phát hiện vi khuẩn hoặc nấm trong máu
Quy trình cấy máu tìm vi khuẩn, nấm
- Thời điểm lấy máu:
- khi bệnh nhân đang sốt hoặc ớn lạnh
- Trước khi dùng kháng sinh.
- Nếu bệnh nhân đang dùng kháng sinh, nên tạm ngưng ít nhất 24 giờ hoặc lấy mẫu ngay trước liều tiếp theo để kết quả chính xác hơn.
- Lấy mẫu máu:
- Lấy máu đảm bảo vô khuẩn tuyệt đối: Máu được lấy từ tĩnh mạch giống như các xét nghiệm thông thường, nhưng yêu cầu khắt khe hơn nhiều về kiểm soát vô trùng.
- Lấy ít nhất là 2 vị trí, số lượng lấy phụ thuộc vào lứa tuổi cân nặng lý tưởng là từ 20 – 30ml với người lớn, và 1 – 3ml với trẻ nhỏ.
Lấy mẫu máu là bước quan trọng để xét nghiệm cấy máu
- Đưa mẫu về phòng xét nghiệm ngay hoặc bảo quản ở nhiệt độ phòng nếu vận chuyển trong thời gian ngắn (không quá 24 giờ).
- Nuôi cấy và theo dõi mẫu tại phòng xét nghiệm: Kỹ thuật viên nuôi cấy mẫu trong môi trường chuyên biệt, theo dõi sự phát triển của vi sinh vật và thực hiện kháng sinh đồ khi có vi khuẩn hoặc nấm phát triển.
Ý nghĩa kết quả xét nghiệm cấy máu
1. Dương tính
- Nếu từ 2 mẫu máu trở lên cùng dương tính với cùng một loại vi khuẩn hoặc vi nấm, gần như chắc chắn bệnh nhân bị nhiễm trùng huyết do tác nhân đó.
- Nếu chỉ có 1 mẫu máu dương tính, trong khi các mẫu khác âm tính, bệnh nhân vẫn có thể bị nhiễm trùng huyết hoặc mẫu lấy không đảm bảo vô khuẩn. Lúc này, bác sĩ thường chỉ định thêm xét nghiệm để xác định chính xác.
- Ngay sau khi có kết quả dương tính, bác sĩ sẽ thực hiện thêm xét nghiệm kháng sinh đồ để xác định loại kháng sinh phù hợp.
Xét nghiệm cấy máu dương tính cho thấy bạn bị nhiễm trùng huyết
2. Âm tính
- Khi tất cả mẫu cấy đều âm tính, khả năng cao bệnh nhân không bị nhiễm khuẩn máu tại thời điểm lấy mẫu.
- Tuy nhiên, nếu bệnh nhân vẫn có triệu chứng lâm sàng nghi ngờ nhiễm trùng huyết, bác sĩ sẽ xem xét lại và có thể chỉ định các xét nghiệm khác để hỗ trợ chẩn đoán.
Xét nghiệm cấy máu chính xác, tin cậy tại Mirai Healthcare
Để đảm bảo kết quả xét nghiệm cấy máu chính xác và nhanh chóng, Phòng khám Đa khoa Mirai Healthcare là địa chỉ đáng tin cậy. Mirai thuộc Tập đoàn Hoken Kagaku Kenkyujo – một trong những tập đoàn y tế uy tín hàng đầu Nhật Bản, cam kết quy trình xét nghiệm chuyên nghiệp, tuân thủ nghiêm ngặt tiêu chuẩn vô trùng trong quá trình lấy và cấy mẫu.
Mirai Healthcare là địa chỉ xét nghiệm cấy máu tin cậy
Phòng khám được trang bị hệ thống thiết bị y tế hiện đại, bao gồm máy cấy máu tự động, giúp đảm bảo kết quả xét nghiệm nhanh chóng và chính xác. Đặc biệt, với dịch vụ lấy mẫu xét nghiệm tận nơi miễn phí, Mirai mang lại sự tiện ích tối đa, giúp bệnh nhân được can thiệp kịp thời mà vẫn an tâm về chất lượng dịch vụ.
Nếu vẫn còn băn khoăn về xét nghiệm cấy máu phát hiện nhiễm khuẩn và nấm vi sinh, bạn hãy liên hệ ngay với Mirai Healthcare hoặc Hotline 1900 9186 để được tư vấn chi tiết.